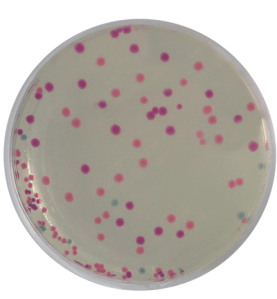

What is transformation?
In nature, some species of bacteria can acquire exogenous DNA from the surrounding environment through a process called transformation. The newly acquired genetic information is both stable and heritable.
In the laboratory, scientists can force bacteria like E. coli to take up DNA and become transformed, even though many bacteria are not naturally competent. It is believed that the combination of calcium chloride and a rapid change in temperature—or “heat shock”—alters the permeability of the cell wall and membrane, allowing DNA molecules to enter the cell.
What is a plasmid?
In addition to their chromosomal DNA, many bacteria possess extra, non-essential genes

on small, circular pieces of double-stranded DNA. These pieces of DNA, known as plasmids, allow bacteria to exchange beneficial genes. For example, some genes that confer antibiotic resistance can be transferred between bacteria on plasmids. Today, scientists use these plasmids for genetic engineering. For more information on plasmids, see our Plasmid Primer!
What is genetic engineering?
Genetic engineering is the use of biotechnology to alter an organism’s DNA. Recombinant DNA technology has allowed scientists to insert genes from different sources into bacterial plasmids. Once transformed, the bacteria can produce large amounts of important proteins from such plasmids, essentially converting cells into living factories. Insulin, which is used to control diabetes, was the first medication for human use to be produced by genetic engineering.
Recently, synthetic biologists have engineered a variety of colorful proteins to be used in biology. First, scientists searched a DNA sequence database to identify genes that
were predicted to produce colored proteins. Fragments of these genes were linked together to create small chimeric proteins (about 27 kilodaltons in mass). These novel genes were cloned into a plasmid and transformed into E. coli. When the cells were examined, the synthetic biologists had created a wide variety of fluorescent proteins that
would be useful for biology experiments. Interestingly, the scientists had also created several chimeric genes that produced highly pigmented cells. These colorful, chromogenic proteins were visible by the naked eye, meaning that a UV light source or fluorescent microscope was not necessary for visualization (Figure 3). Chromogenic proteins are already used in biotechnology as controls for protein expression and as visual markers for protein purification. As the technology becomes more common, they may become important markers for in vivo gene expression studies.

5 comments
Comments are closed.